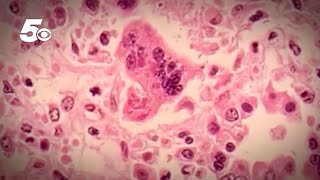

ADH confirms fourth measles case in the state video
Online izle ve mp4 mp3 formatlarinda yukle
Videonun muddeti: 1:04
ADH confirms fourth measles case in the state videosu mp4 ve mp3 yuklemek ucun hazirdir
Diqqet! Siz Mp4 yukle ve ya Mp3 yukle duymesine basdiqdan sonra eger sistem sizi reklam sehifesine atarsa o zaman derhal geri qayidib emeliyyati tekrar edin ve faylin yuklemek ucun hazir olmasini gozleyin
Videodan Mp4 Yukle
Videodan Mp3 Yukle-1
Videodan Mp3 Yukle-2
Oxshar Axtarishlar
ADH confirms fourth measles case in the state
ADH confirms fourth measles case in Arkansas
Arkansas health officials confirm fourth measles case
CDC confirms 1,044 measles cases so far this year
Health officials confirm fourth measles case in Maryland, warn of possible exposures
Measles outbreak reaches 800 cases nationwide: CDC
Gov. Hochul sounds alarm for measles vaccine amid 4 confirmed cases
Measles outbreak in the US: More than 480 cases confirmed in 19 states
Four confirmed measles cases in East Tennessee
Video Mp4 Mp3Azwap.Biz
Azwap.Biz 2021-2023